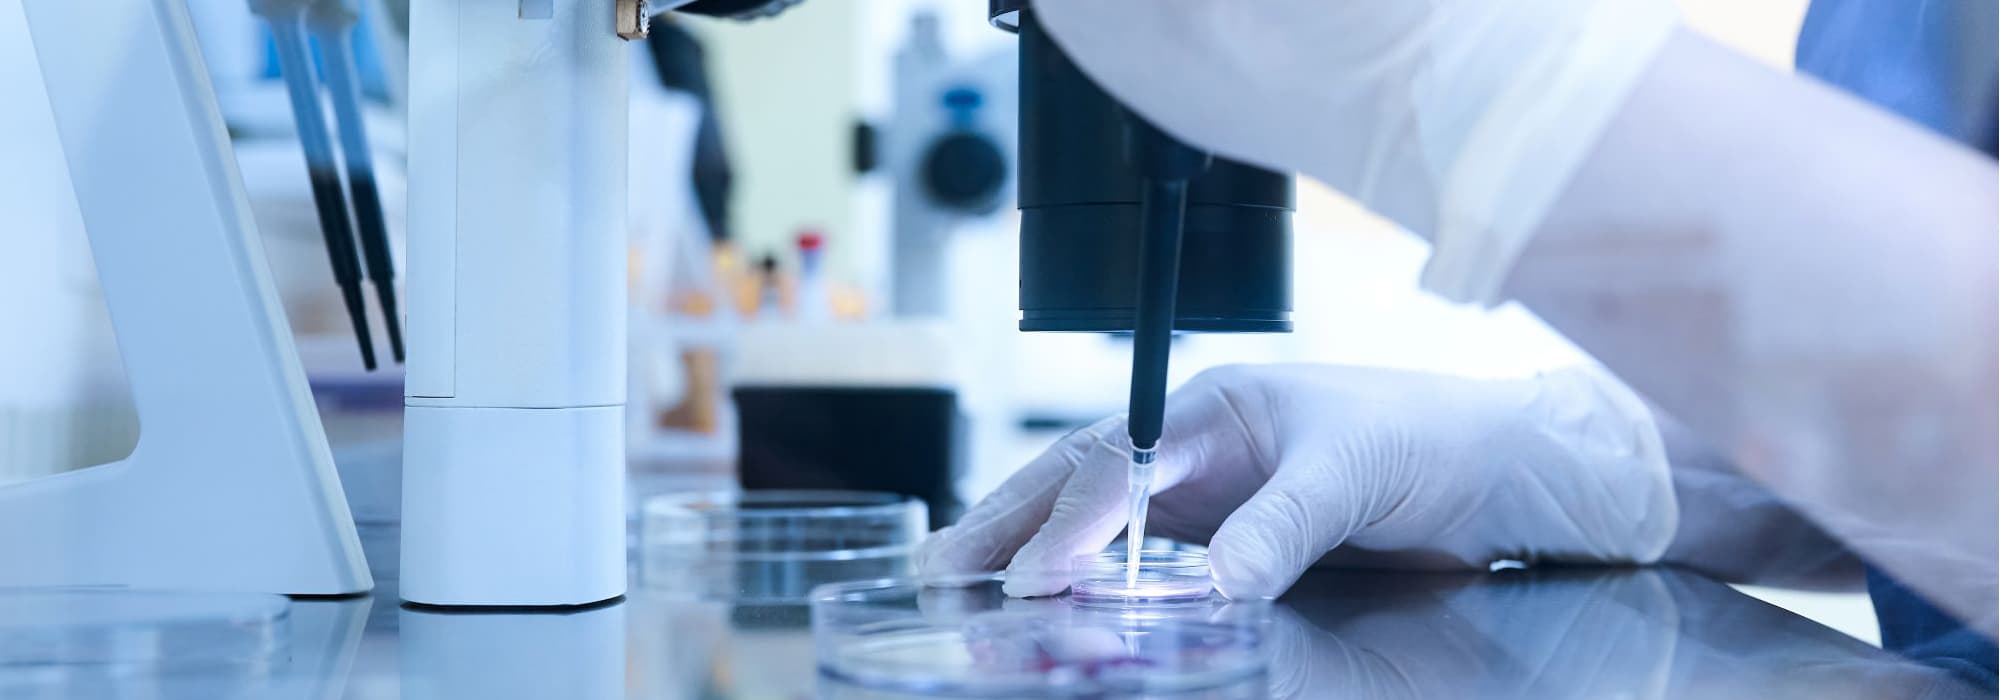

FAMILY BUILDING
Family Building for Lesbians
Your Family-Building Options
As a lesbian couple, you have multiple paths to parenthood. The best option depends on your preferences, medical history, age, and how you envision your family’s story.
Reciprocal IVF
Reciprocal IVF is a unique option that allows both partners to participate in the pregnancy process. One partner provides the eggs (genetic mother), and the other carries the pregnancy (birth mother). This creates a meaningful biological connection for both partners.
IUI with Donor Sperm
Intrauterine insemination with donor sperm is often the first-line treatment. It is less invasive and more affordable than IVF, making it an excellent starting point for many couples.
- Natural cycle IUI or medicated cycle IUI
- Anonymous or known donor sperm
- Multiple attempts may be recommended
IVF with Donor Sperm
IVF may be recommended if IUI is unsuccessful, if there are medical reasons, or if you prefer higher success rates per cycle. IVF also allows for genetic testing of embryos.
Choosing a Sperm Donor
- Access to reputable sperm banks with extensive donor profiles
- Comprehensive medical and genetic screening of all donors
- Open ID donors available for future child contact
- Known donor options with proper legal agreements
Legal Protections
We collaborate with reproductive attorneys to ensure both partners’ parental rights are properly established, including second-parent adoption guidance where applicable.
Take the Next Step
Schedule a consultation with our fertility specialists to discuss your personalized treatment plan.